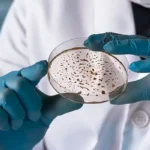
close up of hands holding a petri dish for examination

The Department of Biological Sciences offers Doctor of Philosophy (PhD) programs in biology with focuses in the areas of Microbiology, Cell and Molecular Biology and Ecology, Evolution and Behavior. Prospective students are encouraged to visit faculty webpages in their area of interest.
Admission Requirements
Upon acceptance to the program, students will be notified of any curricular pre-requisites that must be completed as perceived by their advisor/committee. Extra programmatic requirements (physics, organic chemistry and calculus) will be determined by the student’s major professor. All basic requirements must be remedied by the end of the student’s first year.
Graduate School Requirements
There are a number of general Graduate School regulations and requirements for the doctoral degree that are described on the Graduate School website. The student’s program is governed by the rules in the Graduate School’s Academic Policies & Procedures issued the year in which the student enrolled in the graduate program.
Research Requirement
The doctoral degree is a research degree. The most important requirement is that a student must make an original, publishable contribution to their field of study. PhD students are required to have submitted or published at least one primary authored manuscript in a peer-reviewed journal prior to graduation. PhD students are also required to present a Colloquium in the Department of Biological Sciences prior to graduation.
Doctoral Student Status
- Doctoral Student
The Department considers students admitted to the doctoral program with a BS, BA or MS degree to be doctoral students. However, the Graduate School considers as doctoral students only those in the PhD program that already have a MS degree or those who have completed 24 credits of graduate work. - Doctoral Candidate
A doctoral candidate must complete the University residence, formal course, and language/data analysis proficiency requirements and pass the entire PhD Preliminary Examination (see below).
-
Biological Sciences, PhDDoctoralOn Campus
Biological Sciences, PhDDoctoralOn Campus